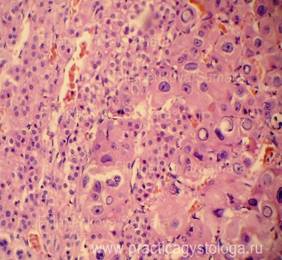

Полезное:
Как сделать разговор полезным и приятным
Как сделать объемную звезду своими руками
Как сделать то, что делать не хочется?
Как сделать погремушку
Как сделать так чтобы женщины сами знакомились с вами
Как сделать идею коммерческой
Как сделать хорошую растяжку ног?
Как сделать наш разум здоровым?
Как сделать, чтобы люди обманывали меньше
Вопрос 4. Как сделать так, чтобы вас уважали и ценили?
Как сделать лучше себе и другим людям
Как сделать свидание интересным?

Категории:
АрхитектураАстрономияБиологияГеографияГеологияИнформатикаИскусствоИсторияКулинарияКультураМаркетингМатематикаМедицинаМенеджментОхрана трудаПравоПроизводствоПсихологияРелигияСоциологияСпортТехникаФизикаФилософияХимияЭкологияЭкономикаЭлектроника

Надпочечники
|
|
1. Какие слои надпочечника представлены в срезах (корковый и мозговой, преобладает корковый слой), сохранность их строения и взаиморасположения.
2. Степень кровенаполнения (очаговое или диффузное капиллярно-венозное полнокровие, умеренное кровенаполнение, слабое кровенаполнение), нарушения реологических свойств крови (эритростазы с диапедезными микрогеморрагиями, лейкостазы, разделение крови на плазму и форменные элементы, плазмостазы).
3. Наличие делипидизации (делипоидизации) цитоплазмы адренокортикоцитов пучковой зон коры надпочечника (слабая, умеренная и выраженная, очаговая, очагово-диффузная, субтотальная и тотальная).
4. Наличие патологических состояний (некрозы, кровоизлияния, клеточная реакция в них, светлоклеточная и темноклеточные аденомы, метастазы опухолей и др.).
Пример№1.
НАДПОЧЕЧНИК (1объект) -в срезах правого и левого надпочечников картина синдрома Уотерхауса-Фридериксена: чередующиеся выраженные очагово-диффузные деструктивные кровоизлияния насыщенно-красного и тёмно-красного цвета, с частичным гемолизом эритроцитов, умеренным и выраженным лейкоцитозом, очаги некроза коркового слоя надпочечников с умеренной и выраженной перифокальной лейкоцитарной инфильтрацией.Неравномерное кровенаполнение ткани надпочечников: чередование участков слабого его кровенаполнения и очагов капиллярно-венозного полнокровия. Неравномерно выраженная делипидизация (делипоидизация) цитоплазмы адренокортикоцитов пучковой зоны коры.

| 
|
| Рис. 1, 2. Надпочечник, корковый слой. Синдром Уотерхауса-Фридериксена. Окраска: гематоксилин и эозин. Увеличение х100 и х250. |
Пример№2.
НАДПОЧЕЧНИК (1объект) - в срезах представлен преимущественно корковый слой надпочечника с преобладанием слабого его кровенаполнения. Строение коркового слоя не нарушено. Субтотальная выраженная делипидизация цитоплазмы адренокортикоцитов клубочковой и пучковой зон коры.

| Рис. 3. Фрагмент коркового слоя надпочечника в состоянии слабого кровенаполнения. Субтотальная выраженная делипидизация цитоплазмы адренокортикоцитов клубочковой и пучковой зон коры. Окраска: гематоксилин и эозин. Увеличение х250. |
Пример№3.
НАДПОЧЕЧНИК (1объект) - в срезах представлены преимущественно корковый слой надпочечника, небольшие фрагменты его мозгового слоя, в состоянии очагово-диффузного неравномерного капиллярно-венозного полнокровия, в ряде сосудов эритростазы, немногочисленные диапедезные микрогеморрагии. Неравномерно выраженная делипидизация цитоплазмы адренокортикоцитов клубочковой и пучковой зон коры. На границе коркового и мозгового слоёв надпочечника крупные очаги метастазов неороговевающего плоскоклеточного рака.

| 
|
| Рис. 4, 5. Метастазы плоскоклеточного неороговевающего рака лёгкого в правый и левый надпочечники (стрелки). Окраска: гематоксилин и эозин. Увеличение х100 и х250. |
Пример№4.
НАДПОЧЕЧНИК (1объект) - в срезах представлены преимущественно значительно утолщенный корковый слой надпочечника в состоянии неравномерного кровенаполнения (участки слабого кровенаполнения граничат с очагами капиллярно-венозного полнокровия). Слабый и слабо-умеренный очаговый отёк стромы. На большей площади срезов представлен распространённый фрагмент светлоклеточной аденомы надпочечника: обилие кучно расположенных крупных клеток по типу адренокортикоцитов, цитоплазма которых переполнена липидными (липоидными включениями, как бы «вспенена» ими). В отдельных полях зрения тонкие соединительнотканные перемычки.

| 
|
| Рис. 6, 7. Светлоклеточная аденома надпочечника. Окраска: гематоксилин и эозин. Увеличение х100 и х250. Цветной и чёрно-белый вариант. |
Пример№5.
НАДПОЧЕЧНИК (1объект) - в срезах представлены преимущественно корковый слой надпочечника с неравномерным его кровенаполнением (участки слабого кровенаполнения граничат с очагами капиллярно-венозного полнокровия). Диффузно расположены небольшие и средней величины скопления криптококков, расположенных в просветах капилляров или замещающих группы погибших гепатоцитов: скопления дрожжеподобных клеток округлой формы диаметром 3-10 мкм, окруженных прозрачной желатинообразной капсулой шириной до 50 мкм. Мицелий не обнаружен. Выраженная диффузная (ближе к тотальной) делипидизация клеток клубочковой и пучковой зон коры. Ядра адренокортикоцитов крупные, с явлениями митоза и пикноза. Криптококкоз надпочечника.

| 
|

| Рис. 8-10. Очаговые скопления криптококков в толще ткани коркового слоя надпочечника, в просветах сосудов (стрелки). Окраска: гематоксилин и эозин. Увеличение х250. |
Пример№6.
НАДПОЧЕЧНИК (2объекта, окраска гематоксилин и эозин, Конго-красный) - в срезах представлены преимущественно корковый слой надпочечника с преобладанием сосудов слабого кровенаполнения. Стенки сосудов резко утолщены, с потерей их структуры, пропитаны гомогенным бледно-розовым аморфным веществом при окраске гематоксилином и эозином, при окраске Конго красным - рыже-оранжевого цвета, что подтверждает наличие патологического белка амилоида. Просветы сосудов значительно сужены. Слабая и умеренная делипидизация (делипоидизация) цитоплазмы сохранившихся адренокортикоцитов клубочковой и пучковой зоны коры. В толще стромы коры надпочечника выраженное диффузное отложение амилоида, сдавливающего адренокортикоциты. Слабо-умеренное и умеренное диффузное отложение амилоида в толще капсулы надпочечника.

| 
|

| Рис. 11-15. Амилоидоз надпочечника. Отложение амилоида кирпично-оранжевого цвета по ходу сосудистых стенок, стромы надпочечника, в толще его капсулы. Окраска: Конго-красный. Увеличение х 100 и х 250. |

| 
|

| 
|
| Рис. 16. В толще капсулы надпочечника добавочные интерреналовые тельца (стрелки). Окраска: гематоксилин-эозин. Увеличение х 100. | Рис. 17. Очаговая гемангиома коркового слоя надпочечника (стрелки). Окраска: гематоксилин-эозин. Увеличение х 100. |

| 
|

| Рис. 18-20. Выраженная диффузная (ближе к субтотальной) делипоидизация цитоплазмы клеток коркового слоя надпочечника (стрелки). Кровенаполнение варьирует от участков слабо-умеренного кровенаполнения до очагов резко выраженного капиллярно-венозного полнокровия с эритростазами, лейкостазами. Окраска: гематоксилин-эозин. Увеличение х 250. |

| 
|
| Рис. 21-24. Очаговые гиперплазия, атипия, липофусциноз клеток коркового слоя надпочечника. Окраска: гематоксилин-эозин. Увеличение х 250. | |

|
|

| 
|
| Рис. 25, 26. «Свежие» очаговые некрозы коркового слоя надпочечника на фоне выраженного его очагово-диффузного капиллярно-венозного полнокровия с эритростазами, диапедезными микрогеморрагиями. Окраска: гематоксилин-эозин. Увеличение х 250. |

Date: 2015-07-01; view: 1070; Нарушение авторских прав